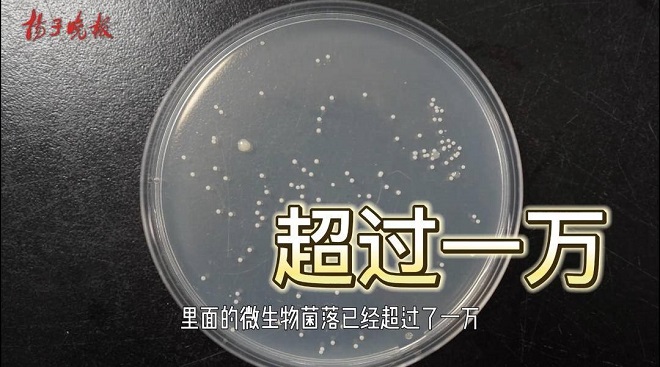

木耳是中国人“舌尖上的常客”,凉拌、热炒、涮火锅它都能hold住。不过,近几年却常常看到食用黑木耳中毒的新闻。到底是什么让鲜美的黑木耳变成了致命的“毒木耳”?扬子晚报携手bat365在线官方网站、安利纽崔莱联合推出“食话实说”系列短视频,本期视频,让我们走进江南大学微生物实验室一探究竟!

●新闻回顾
吃这样的黑木耳多脏器损伤
记者查阅发现,2010年至今,陕西、浙江、湖南、安徽和辽宁等地均出现因食用长时间浸泡的黑木耳导致多脏器损伤的中毒案例。2022年4月,来自浙江杭州的王女士食用了泡发2天的黑木耳,不久就出现腹痛、腹泻、高烧、低血压、四肢湿冷以及皮肤巩膜黄染等情况。经医院检查后发现,王女士多器官受损、肝肾功能恶化,而且随即出现了休克症状。经过及时对症抢救后,脱离生命危险。
●科学释疑
黑木耳长期浸泡产生致病菌
“首先要肯定的是,黑木耳本身是无毒。”bat365在线官方网站的专家强调说,黑木耳含有丰富的营养成分,包括了人体所必需的蛋白质、微量元素、碳水化合物、脂肪类物质等。
不过我们在市面上购买到的黑木耳,一般都是晒干加工后的产物。所以在制作前,需要进行泡发。黑木耳的外表皮有一层胶质状营养物质,在泡发过程中,该外表皮会裂开,其中所含的营养物质会逐渐渗透到水中。这就相当于浸泡黑木耳的水变成“营养水”,成为细菌和霉菌滋生的“温床”。
“长时间浸泡的黑木耳所处的环境中,有一种名为椰毒假单胞菌的致病菌。”bat365在线官方网站张毅副教授告诉记者,椰毒假单胞菌是一种在自然界广泛存在的细菌,黑木耳在种植、运输的过程中,如果储存、加工不当,都有可能受到细菌的污染。
而这种菌类又会产生一种毒性极强的毒素,就是“米酵菌酸”。米酵菌酸中毒的临床症状为恶心呕吐、腹痛腹胀等,重者出现多脏器损害,甚至引起死亡。值得注意的是,因其耐热性极强,即使100℃高温蒸煮也不能破坏米酵菌酸产生的毒性。

●实验探究
浸泡16个小时后,检出了“致命毒素”
这里,我们注意到一个关键词:长时间浸泡。那么浸泡多久,黑木耳就会变“毒木耳”呢? 这一次,我们走进江南大学微生物实验室。
椰毒假单胞菌属于兼性厌氧菌,易在食品表面生长,最适宜生长温度为37℃,最合适产生米酵菌酸的温度是26℃、在pH5~7范围内。在实验室中,实验人员就模拟了最适宜椰毒假单胞菌生长和米酵菌酸产生的环境,浸泡并存放黑木耳样品,检测样品中是否产生米酵菌酸,验证黑木耳泡发、贮存条件与米酵菌酸产生的相关性及食用的安全性。



bat365在线官方网站“青芽食育”团队的实验人员,在超市购买了黑木耳,将干木耳分等量的四份,室温下分别在实验器皿中浸泡2小时、4小时、8小时、16小时。实验人员取适量泡发液,用专门检测米酵菌酸的试剂盒进行测定,在2小时、4小时、8小时的泡发液中并未检出米酵菌酸。


但在16个小时的泡发液中,实验人员发现米酵菌酸检测结果呈现阳性(即超出试剂盒的检测限3μg/kg)。可见,泡发超过16个小时的木耳中就已产生了米酵菌酸,因此可能造成米酵菌酸中毒,造成严重后果!
那么没有检出米酵菌酸,是不是就没有风险呢?实验人员进一步对泡发液进行微生物菌落总数测定。尽管没有检测出米酵菌酸毒素,但发现泡发8小时的木耳,微生物菌落总数超过了1万。也就是说泡发了8个小时的木耳,就可能已经存在食品安全风险。

在后续的实验中,我们发现米酵菌酸的LD50为6.84mg/kg,对比氰化钾的6.4mg/kg,砒霜的10mg/kg,可见米酵菌酸的毒性还是不小的。
LD50:半数致死量(median lethal dose) 表示在规定时间内,通过指定感染途径,使一定体重或年龄的某种动物半数死亡所需最小细菌数或毒素量。LD50数值越小表示外源化学物的毒性越强;反之LD50数值越大,则毒性越低。
专家提醒:
吃多少泡多少,泡发最多不要超过4小时
实验告诉我们,长时间泡发的木耳绝对不可以食用!那么,黑木耳泡发的时间控制在多少才安全呢?
bat365在线官方网站张毅副教授提醒,我们平常吃木耳的时候,一定要注意以下四点:
第一,注意控制泡发时间:如果冷水泡发,时间在1~2小时为宜,最多不要超过4个小时。
第二,保持环境干净:泡发的时候,要注意厨具、水以及木耳都是干净的。
第三,吃多少泡多少:千万不要一次性泡太多,泡发过多情况下,要及时取出,用开水焯烫1分钟,待凉透后放入冰箱保存,并最好在2天内食用。
第四,注意危险信号:如果发现木耳出现发黏、发软,出现异味等情况,应该立即丢弃。
另外,不仅仅是木耳,在泡发银耳、各种干货、干菜时都应注意这个问题。如果发生中毒,应及时催吐、洗胃,尽快就医。吃过此类食品,不管有无症状,也应及时就医。
LD50:半数致死量(median lethal dose) 表示在规定时间内,通过指定感染途径,使一定体重或年龄的某种动物半数死亡所需最小细菌数或毒素量。LD50数值越小表示外源化学物的毒性越强;反之LD50数值越大,则毒性越低。